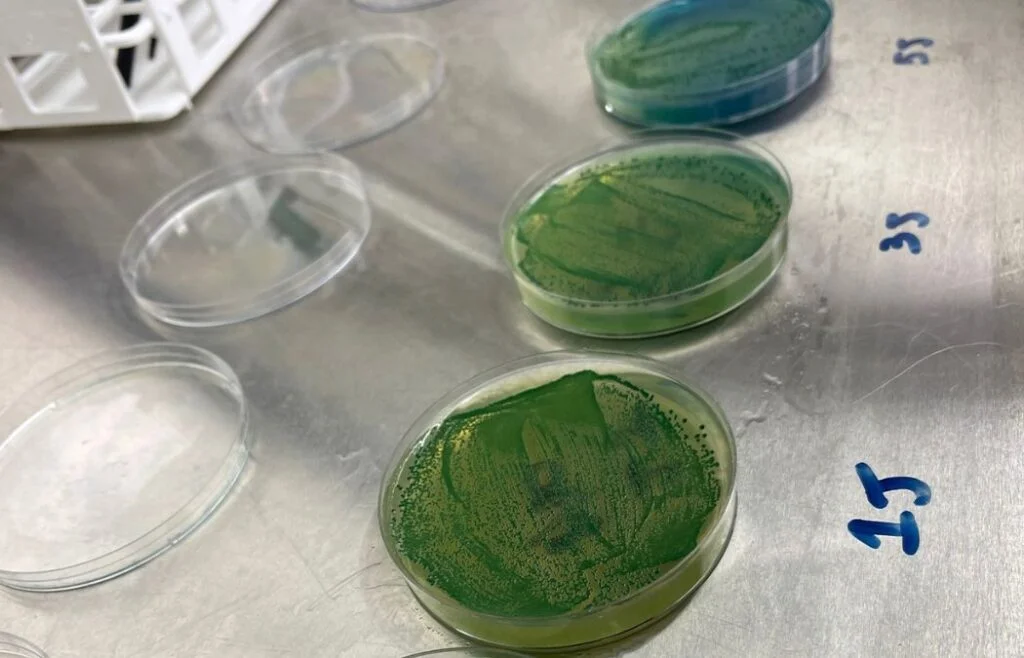

Well, Columbus. It’s official. We are living in the future.
Species X Beer Project is a new brewery that just opened in Columbus, and the concept is equally as awesome as it is crazy.
The name comes from their brewing philosophy. Essentially, there are two “species” of beer currently being brewed, the Silicon Species and the Carbon Species.

The Silicon Species of beer is created solely through artificial intelligence and machine learning, which develops completely unique beer recipes. Each AI model is giving distinct guidelines to follow, such as creating IPAs, Lagers, Sours, or an entirely new “species” of beer that we have never encountered before.
The Carbon Species are acquired through various processes such as hybridization, genetic engineering, mutagenesis, novel capture, and spore germination. Basically, these are different methods of creating and utilizing various yeast cultures, which is why it is dubbed the Carbon Series (as all living organisms are comprised of carbon).
All of this is to say that Species X Beer Project is pushing the limits for what beer currently is and finding unique ways to change the way we experience beer in the future. One incredible example of this is by finding “sleeping” yeast cultures in ancient artifacts, harvesting them, and essentially bringing them back to life. Then, they brew beer with these cultures, allowing us to get a glimpse into the past of what beers tasted like through Species X’s futuristic technology.

I know. All of this sounds like the plot of a Christopher Nolan movie. But alas, this is just everyday life for Species X Beer Project in Columbus, Ohio
If you’d like to learn more about Species X Beer Project, you can visit their immersive website here, read through their menu here, or visit their brewery at 408 N 6th St, Columbus, OH 43215.


